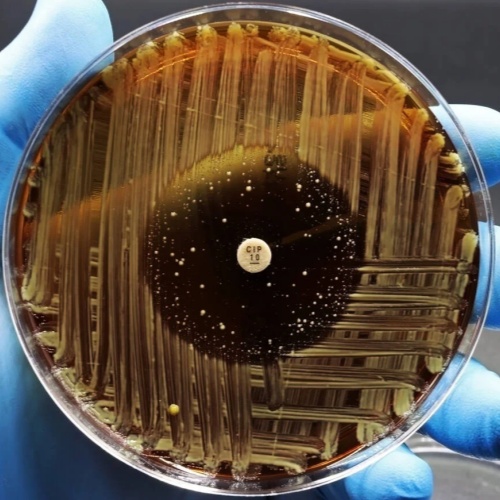

在全球抗生素耐药问题日益严峻的背景下,科学家们正在不断探索新的抗菌策略。近期一项研究发现,在一种经典抗生素的合成过程中,某些“中间产物”可能比最终成品更具抗菌活性,这一发现或将推动抗生素研发思路的转变。
一、研究背景:从传统抗生素中寻找新突破
研究对象为经典抗生素 Methylenomycin A。该物质来源于放线菌 Streptomyces coelicolor,早在约50年前就已被发现,具有对革兰阳性和革兰阴性细菌的抗菌作用。
本研究由英国University of Warwick与澳大利亚Monash University的科研团队合作完成,重点探究该抗生素生物合成途径中的关键酶作用。
二、重要发现:意外出现的高效“中间产物”
研究团队通过“关闭”部分生物合成相关基因,成功在合成过程中发现了两种此前未知的中间产物:
Prämethylenomycin C(前甲烯霉素C),
其对应的内酯前体。
令人惊讶的是,这些中间产物不仅具有抗菌活性,而且:
对部分革兰阳性细菌的抑制作用,
比最终产物强约100倍。
这一结果颠覆了传统认知——通常认为最终产物才是最具活性的形式。
三、对耐药菌的显著效果
进一步实验显示,这些中间产物对多种耐药菌也具有显著活性,包括:
Methicillin-resistant Staphylococcus aureus(耐甲氧西林金黄色葡萄球菌),
Vancomycin-resistant Enterococci(耐万古霉素肠球菌)。
其中,前甲烯霉素C内酯在实验室条件下对以下病原体表现出极高活性:
金黄色葡萄球菌耐药株(MRSA),
粪肠球菌(Enterococcus faecium)。
其最小抑菌浓度(MIC)仅为1~2 μg/mL,属于较强抗菌水平。
四、为何中间产物更有效?
研究人员推测,这些中间产物在结构上可能具有以下优势:
更易与细菌靶点结合,
更高的细胞穿透能力,
较少被细菌耐药机制识别或降解。
同时,这也提示:在天然产物的生物合成过程中,“未完成”的分子可能反而更具药理潜力。
五、对抗生素研发的启示
这一发现具有重要意义,可能带来抗生素研发范式的改变:
传统路径:寻找最终代谢产物作为药物,
新思路:系统筛选合成路径中的中间体。
研究团队指出:
通过分析不同天然产物的合成路径,
识别并测试其中的中间产物,
可能发现更多高效、抗耐药的新型抗生素。
六、未来研究方向
尽管实验结果令人振奋,但仍处于早期阶段,后续仍需:
开展系统的药理学研究,
评估毒性与安全性,
进行动物实验(临床前研究),
最终进入临床试验验证疗效。
特别是前甲烯霉素C内酯,已被视为潜在的新药候选分子。
七、总结
这项研究表明,在抗生素的生物合成过程中,中间产物可能比最终产物更具抗菌活性,甚至对多种耐药菌表现出强效抑制作用。
这一发现不仅为开发新型抗生素提供了重要线索,也提示科研人员应重新审视天然产物的研究策略。在抗生素耐药问题日益严峻的今天,这种“从源头重新挖掘”的思路,或将成为未来抗感染药物研发的重要方向。